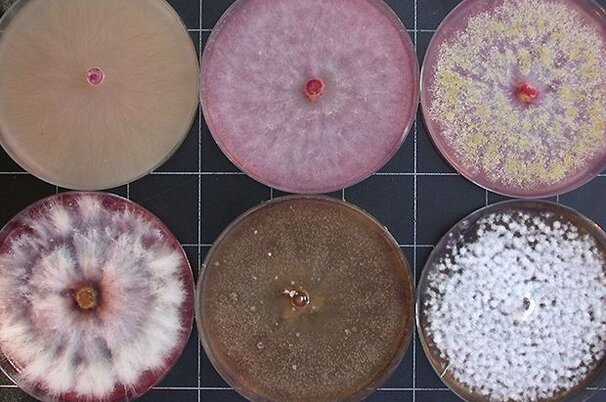
53356_8.jpg

Artikel werden durchsucht.
Politik & Wirtschaft
International
2015 hat Hitzerekorde geknackt
Pflanzen
Forschung
Pilzresistente Weizensorten als Ziel
Politik & Wirtschaft
International
Bauernprotest weitet sich aus
Vermischtes
Allerlei
US-Ostküste versinkt im Schnee
Politik & Wirtschaft
Milchmarkt
Weltmarktpreise für Milchprodukte kommen nicht in Schwung
Politik & Wirtschaft
Agrarwirtschaft
Die Lawine im Griff
Politik & Wirtschaft
Agrarwirtschaft
Ritter musste Machtwort sprechen
Vermischtes
Allerlei
USA: Monster-Schneesturm erwartet
Politik & Wirtschaft
Agrarpolitik
EU will Agrarpolitik vereinfachen
Politik & Wirtschaft
Milchmarkt
Den EU-Milchbauern gehts ebenso schlecht
Das Wetter heute in
Lesershop
Umfrage

Schaut Ihr Landfrauenküche?
- Ja, jede Folge:71.63%
- Ja, ab und zu:17.3%
- Nein, interessiert mich nicht:11.07%
Teilnehmer insgesamt: 2711
Bekanntschaften
Suchen Sie Kollegen und Kolleginnen für Freizeit und Hobbies? Oder eine Lebenspartnerin oder einen Lebenspartner?